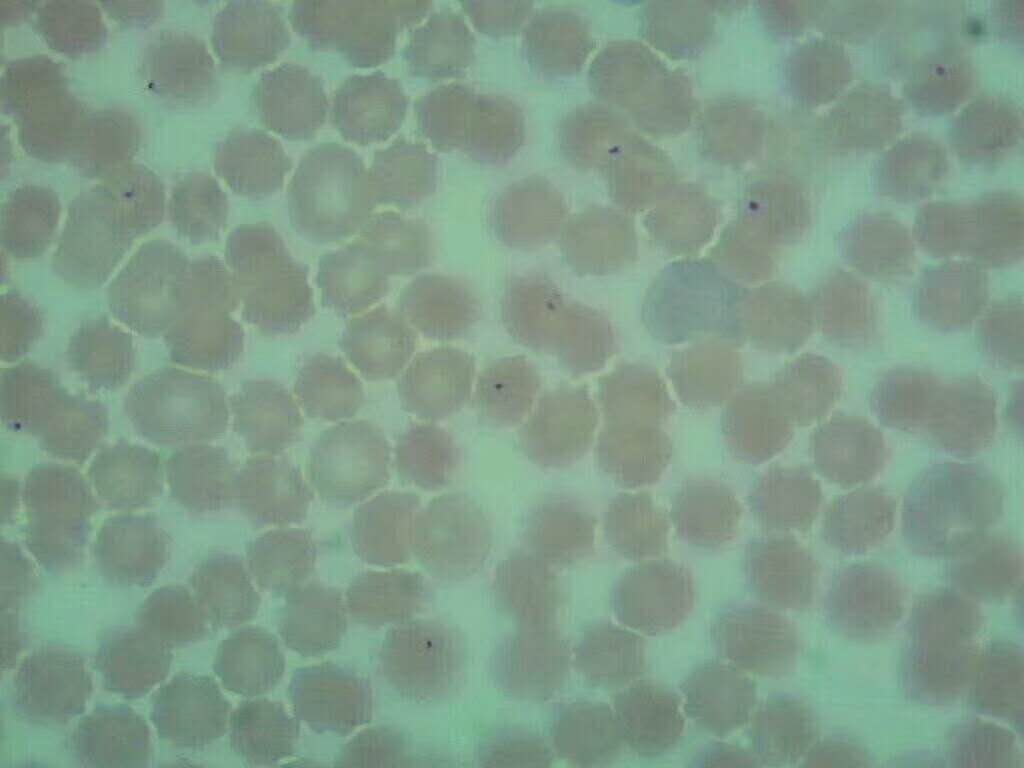
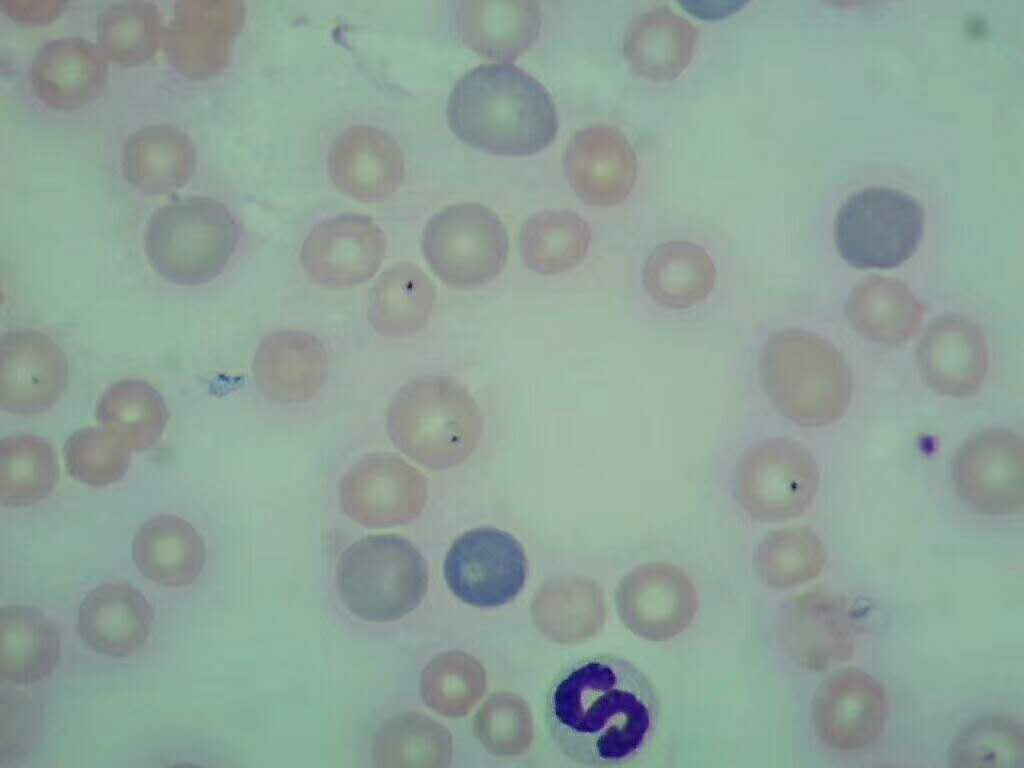

血蟲學名:巴貝斯焦蟲,由蜱蟲(草爬子)叮咬動物傳播,寄生在血液紅細胞內(nèi),破壞紅細胞,導致溶血貧血,黃疸,如不及時治療,*引起多個器官的衰竭死亡。下圖是*近接的幾例血蟲病例,都有蜱蟲叮咬史,無正常體外驅(qū)蟲。再次強調(diào):正常程序的體外驅(qū)蟲能夠有效的避免蜱蟲的叮咬,減少血蟲的發(fā)病率

本文是【http://www.bbgppm.com 河南狗博仕寵物醫(yī)院有限公司】原創(chuàng),轉(zhuǎn)載時請務(wù)必以鏈接形式注明作者和出處
地 址:http://www.bbgppm.com/home-newsinfo-id-126.html